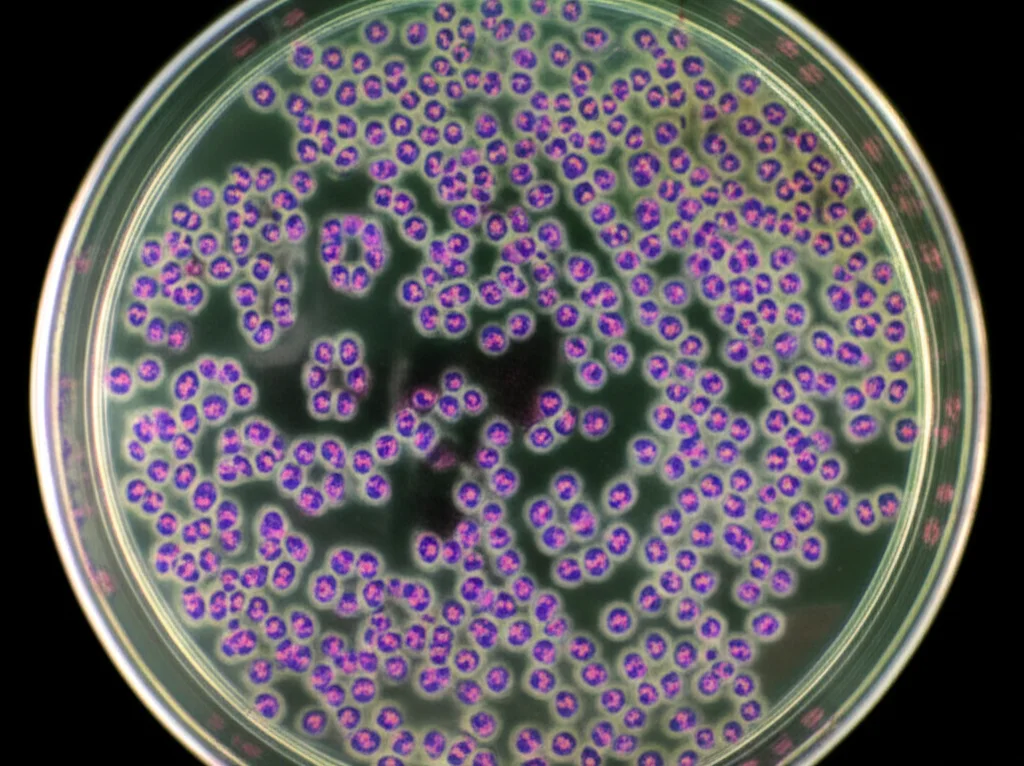
Scatto con obiettivo macro da 100mm che mostra piastre di Petri sotto un microscopio. A fuoco ci sono cellule di adenocarcinoma gastrico, alcune delle quali mostrano chiari segni di apoptosi (forma arrotondata, piccole vescicole sulla membrana). Illuminazione da laboratorio controllata, messa a fuoco precisa sulle cellule alterate, alta definizione.

Urolitine: L’Arma Segreta dalla Frutta che Sfida il Cancro allo Stomaco?
Ciao a tutti! Oggi voglio portarvi con me in un viaggio affascinante nel mondo della ricerca oncologica, un campo dove ogni piccola scoperta può accendere una grande speranza. Parleremo di qualcosa che forse avete già sentito nominare, le urolitine, e di come queste molecole naturali, derivate da frutta e noci che magari mangiamo tutti i giorni, potrebbero avere un ruolo inaspettato nella lotta contro un nemico temibile: l’adenocarcinoma gastrico (GAC).
Pensate, il cancro allo stomaco è tra i tumori più comuni e letali al mondo. Nonostante i progressi, le terapie attuali hanno ancora molti limiti, come la resistenza ai farmaci e pesanti effetti collaterali. Ecco perché la ricerca di nuove armi è così cruciale. E se una di queste armi si nascondesse proprio nel nostro cibo?
Il “Cattivo” della Storia: Il Recettore MET
Nel complesso puzzle del cancro gastrico, un pezzo importante è rappresentato da un recettore chiamato MET (Hepatocyte Growth Factor Receptor). Immaginatelo come un interruttore sulla superficie delle cellule: quando viene attivato in modo anomalo, può dare il via a una serie di eventi che favoriscono la crescita del tumore, la sua diffusione (metastasi) e la resistenza alle terapie. Purtroppo, questo recettore è spesso “iperattivo” o presente in quantità eccessive in molti pazienti con GAC, ed è associato a prognosi peggiori. Nonostante sia un bersaglio così ovvio, ad oggi non ci sono farmaci specifici approvati che lo colpiscano efficacemente nel cancro gastrico. Una bella sfida, vero?
Entrano in Scena le Urolitine: Eroi Naturali?
Ed è qui che entrano in gioco le nostre protagoniste: le urolitine. Cosa sono? Sono dei metaboliti speciali che il nostro corpo (o meglio, i batteri buoni del nostro intestino) produce a partire dall’acido ellagico. E dove si trova l’acido ellagico? In frutti come melograni, fragole, lamponi, e in noci come le noci comuni. La cosa interessante è che le urolitine, in particolare l’Urolitina A (UA) e l’Urolitina B (UB), sembrano essere assorbite meglio dal nostro corpo rispetto all’acido ellagico da cui derivano.
Negli ultimi anni, queste molecole hanno attirato molta attenzione per le loro proprietà benefiche: antiossidanti, antinfiammatorie, neuroprotettive… e sì, anche anticancerogene! Studi precedenti hanno mostrato che possono mettere i bastoni tra le ruote a diversi tipi di tumore (colon, fegato, prostata, seno…). Ma come fanno? Sembra che agiscano su più fronti, regolando geni importanti per la crescita tumorale, inducendo le cellule cancerose a “suicidarsi” (un processo chiamato apoptosi) e interferendo con i segnali di crescita.
La domanda che ci siamo posti, e che è al centro dello studio che vi racconto, è stata: potrebbero le urolitine essere efficaci contro l’adenocarcinoma gastrico proprio andando a colpire il recettore MET?

Indagini da Detective: L’Analisi Computazionale (In Silico)
Prima di passare ai test in laboratorio, abbiamo indossato i panni dei detective digitali. Utilizzando potenti strumenti bioinformatici, abbiamo fatto diverse cose:
- Abbiamo cercato tutti i possibili bersagli molecolari delle urolitine (UA, UB e una loro parente, la metil-UA o mUA).
- Abbiamo identificato i geni associati all’adenocarcinoma gastrico.
- Abbiamo incrociato questi dati per vedere se c’erano bersagli comuni. E indovinate un po’? Ne abbiamo trovati 19, e tra i più importanti (“hub genes”) c’era proprio lui: il nostro recettore MET!
- Abbiamo costruito una rete di interazioni tra queste proteine (PPI network) per capire meglio le loro connessioni.
- Abbiamo analizzato quali processi biologici e percorsi molecolari fossero più influenzati da questi geni comuni, confermando il ruolo centrale di MET in vie legate al cancro.
- Abbiamo verificato, usando database pubblici di espressione genica (GEO), che le cellule di adenocarcinoma gastrico che avremmo usato nei test (le MKN-45) avessero effettivamente alti livelli di MET. E così era! Al contrario, altre cellule tumorali usate per confronto (MG-63, osteosarcoma) ne avevano bassi livelli.
- Infine, abbiamo valutato al computer le proprietà delle urolitine come potenziali farmaci (ADMET): buona lipofilia (capacità di sciogliersi nei grassi), solubilità in acqua ragionevole, buon assorbimento intestinale previsto e, cosa importante, nessun segnale preoccupante di tossicità. Insomma, sembravano delle buone candidate!
Questa prima fase ci ha dato una solida base teorica: MET è un bersaglio chiave sia per il GAC che per le urolitine, e queste molecole sembrano avere le carte in regola per diventare farmaci.
La Prova del Nove: Esperimenti in Laboratorio (In Vitro)
Con queste premesse incoraggianti, siamo passati al bancone del laboratorio. Abbiamo sintetizzato le nostre urolitine (UA, UB e mUA) e le abbiamo testate su diverse linee cellulari:
- MKN-45: Cellule di adenocarcinoma gastrico con alti livelli di MET.
- MG-63: Cellule di osteosarcoma (un altro tipo di cancro) con bassi livelli di MET, usate come controllo.
- HFF-3: Cellule normali di fibroblasti della pelle, per verificare la tossicità su cellule sane.
Abbiamo esposto queste cellule a concentrazioni crescenti di urolitine per diversi periodi (24, 48, 72 ore) e abbiamo misurato la loro vitalità. I risultati sono stati davvero interessanti!
Le urolitine hanno mostrato una tossicità dose-dipendente e tipo-cellulare-dipendente. Cosa significa? Che più alta era la dose, maggiore era l’effetto, ma soprattutto, che le cellule MKN-45 (quelle con tanto MET) erano le più sensibili! L’Urolitina A (UA), in particolare, si è dimostrata la più potente nel ridurre la vitalità di queste cellule tumorali gastriche. Al contrario, le cellule MG-63 (con poco MET) erano meno sensibili, e le cellule normali HFF-3 sono state toccate solo marginalmente (soprattutto da UB, mentre UA e mUA a 100 µM per 72 ore non hanno mostrato tossicità significativa).
Ma come uccidevano le cellule tumorali? Abbiamo usato una tecnica chiamata citometria a flusso per scoprirlo. Trattando le cellule MKN-45 con 100 µM di UA per 72 ore, abbiamo visto che una percentuale enorme (circa il 64%) andava incontro ad apoptosi, la morte cellulare programmata. Un segnale ottimo, perché è proprio quello che vogliamo da un farmaco antitumorale: che elimini le cellule malate inducendole al “suicidio”. Anche UB e mUA inducevano apoptosi, sebbene in misura minore rispetto a UA su queste cellule. Sulle cellule MG-63, invece, l’effetto era molto più blando, con UA che induceva principalmente necrosi (un tipo di morte cellulare meno “pulito”) in una piccola percentuale di cellule.
Questi risultati in vitro confermavano l’ipotesi: le urolitine, specialmente UA, sono tossiche per le cellule di cancro gastrico che esprimono alti livelli di MET, e lo fanno inducendo apoptosi.
Il Legame Decisivo: Urolitine e MET Faccia a Faccia
A questo punto, avevamo forti indizi: MET è sovraespresso nelle cellule GAC, le urolitine sono più tossiche proprio su queste cellule, e le analisi computazionali suggerivano un legame. Mancava la prova del “contatto” diretto. Per ottenerla, abbiamo usato il docking molecolare, una simulazione al computer che cerca di prevedere come una piccola molecola (come l’urolitina) possa legarsi a una proteina (come MET).
I risultati? Sorprendenti! Sia l’Urolitina A che l’Urolitina B hanno mostrato di potersi “incastrare” perfettamente nel sito attivo di MET, la regione cruciale per la sua funzione. L’UA, in particolare, formava legami idrogeno con residui aminoacidici chiave (Tyr1234 e Tyr1289) all’interno del sito attivo, con un’affinità di legame (-5.4 kcal/mol) paragonabile a quella di Sunitinib (-5.3 kcal/mol), un farmaco inibitore di MET usato come controllo positivo! Anche UB si legava, sebbene con un’affinità leggermente inferiore (-4.5 kcal/mol).
Per essere ancora più sicuri, abbiamo fatto un passo ulteriore con le simulazioni di dinamica molecolare per il complesso UA-MET. Queste simulazioni, che durano nanosecondi ma richiedono enormi potenze di calcolo, mimano il movimento degli atomi nel tempo. Hanno confermato che il legame tra UA e MET è stabile e che la molecola di UA rimane ben posizionata all’interno del sito attivo, pur mantenendo una certa flessibilità. L’analisi ha mostrato che l’interazione è continua per tutto il tempo della simulazione.
Questo è un punto cruciale: legandosi al sito attivo, le urolitine potrebbero impedire a MET di attivarsi correttamente e di inviare quei segnali che promuovono la crescita tumorale. È come mettere una chiave sbagliata nella serratura, bloccandola.

Cosa Significa Tutto Questo e Quali Sono i Prossimi Passi?
Mettendo insieme tutti i pezzi – l’importanza di MET nel GAC, le proprietà promettenti delle urolitine, la loro maggiore efficacia sulle cellule con più MET, l’induzione dell’apoptosi e la dimostrazione (prima computazionale e poi simulata dinamicamente) del legame diretto con il sito attivo di MET – emerge un quadro davvero entusiasmante.
Questo studio suggerisce fortemente che le urolitine, molecole derivate da alimenti comuni, potrebbero esercitare i loro effetti antitumorali sull’adenocarcinoma gastrico proprio interagendo con il recettore MET e potenzialmente inibendone l’attività. È la prima volta che viene proposto questo meccanismo specifico per le urolitine nel contesto del GAC.
È una notizia fantastica, perché apre la strada a nuove strategie terapeutiche. Immaginate di poter usare composti naturali, magari ottimizzati in laboratorio, per colpire un bersaglio così importante come MET, per il quale mancano ancora farmaci specifici approvati per il GAC. Potrebbe essere un modo per migliorare l’efficacia delle cure e ridurre gli effetti collaterali.
Certo, siamo ancora all’inizio. Come sottolineano gli stessi ricercatori, questo è uno studio di base. Serviranno ulteriori ricerche per confermare questi risultati:
- Test su cellule epiteliali gastriche normali per essere sicuri della selettività.
- Esperimenti più specifici in cui si “spegne” (knockdown) o si “accende” (sovraespressione) il gene MET nelle cellule tumorali per vedere se l’effetto delle urolitine cambia di conseguenza.
- E, naturalmente, studi preclinici su modelli animali e poi, si spera, studi clinici sull’uomo.
La strada è ancora lunga, ma la direzione sembra promettente. Le urolitine ci ricordano ancora una volta come la natura possa essere una fonte incredibile di molecole preziose per la nostra salute, anche nella lotta contro malattie complesse come il cancro. Continueremo a seguire questi sviluppi con grande interesse!
Fonte: Springer







